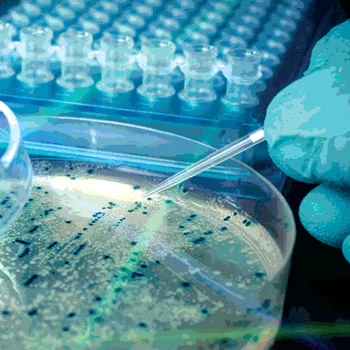

Food Testing: Selecting a Contract Laboratory
Most food, beverage and ingredient manufacturers need outside laboratory support at some time or another. This includes small, medium and large processors. The type of support processors require may be microbiological, chemical, nutritional, product development or any other type of analysis.
So how should a food processor select a laboratory to support their operations? The answer is not and should not be “pick one off the Internet or out of the telephone book.” There are cases in which a company may simply pick a laboratory, but it is really not the best option. Some processors have established “approved laboratory” programs, that is, they mandate that their suppliers use only laboratories that they have vetted and approved. However, even those operations that are required to use an approved laboratory should not simply pick one but should go through a process of evaluation, review and approval. In other words, treat a contract laboratory as one would any supplier of foods, ingredients, raw materials and packaging materials: subject the laboratory to the same rigor that one would apply to selecting, evaluating, approving and managing any vendor. Visit the laboratory or at a minimum engage them in a telephone conversation where you can evaluate their capabilities and their understanding of your situation. In fact, it would not be out of line to treat laboratories using the same protocols described in Subpart G of the current Good Manufacturing Practices Hazard Analysis and Risk -Based Preventive Controls for Human Food.[1]
Whom to Select
The first step when selecting a vendor is to define needs and develop a list of laboratories that can meet them. What kind of work do you need? Product development services? Microbiological testing? Design and implementation of an environmental monitoring program? Preparation of a certificate of analysis (COA) for customers? Development of a nutrition facts statement for a new or reformulated product?
Once a company establishes their needs, the next step is to identify one and preferably several contract laboratories that will meet their needs. But what criteria should a processor look for in their contract laboratory? Let’s assume the goal is selecting a microbiology laboratory. The criteria one might look for are:
• The laboratory is ISO 17025 certified[2]
• The laboratory is capable of doing the work needed using official and recognized methods
• The work can be started as soon as the samples arrive, and results will be available as the testing protocol dictates
• The laboratory can provide references that the company may speak to
• The laboratory will pick up samples
• The laboratory allows audits
• The laboratory has trained employees that participate in check-sample programs
• The laboratory will not only provide results but also will interpret results if needed
• The laboratory demonstrates a sense of urgency with your samples
• The laboratory has experience with your product matrix or matrices that are very similar
• The laboratory has the ability to suggest possibly more appropriate tests in addition to or in place of the testing you are asking for
• Cost of services
There may be other requirements that could be part of the selection criteria, but these 12 are enough to identify the laboratories that are truly qualified to be trusted with your testing.
ISO Certification:[2] ISO 17025 certification has become a standard among laboratories the world over. It indicates that the laboratory has established documented procedures for managing all aspects of laboratory operations, from receipt of samples to testing to reporting. For many people, if a laboratory has achieved an ISO 17025 certification, it is more than enough to approve that lab. The audit process for certification is extremely comprehensive and lengthy. Elements that make up the standard include management requirements, such as the organization, quality systems, document control, subcontracting services, purchasing, complaints, service to the client, control of nonconformance, calibration, corrective actions, preventive actions, control of records, internal audits and management review. Technical issues also subject to the audit are personnel, environmental conditions, test and calibration methods, equipment, measurement traceability, sampling, handling of test and calibration items, ensuring test results and reporting. All of these elements must be developed, documented and implemented, and maintained. Maintenance is a function of management commitment, verification activities and internal audits to ensure that programs are being followed.
ISO 17025 certification is specific to each test. Just being ISO certified does not mean that all the tests being conducted in the laboratory have been certified. Have the laboratory define the scope of the testing procedures that have been ISO certified. At a minimum, pathogen analysis should be included in the ISO 17025 scope for the laboratory certification. Routine tests may or may not necessarily be included in the scope of certification. Laboratories may exclude routine tests such as total counts, yeast and mold from the scope of testing due to the requirement and cost for including those tests in the required third-party, check-sample program.
Capabilities: The biggest issue should be the laboratory’s ability to do the work and do it well. The company must use official and recommended methods, and provide reports that not only provide results but also reference how the work was done. It is up to the client to clearly define what they want done, however. This may be a challenge for small companies or those that do not have a good technical staff. A good contract laboratory should work with potential clients during this initial phase to understand their needs and limitations. Hopefully, the laboratory will not take advantage of the potential client.
Most people tend to think of sample testing when considering a microbiology laboratory, but one should consider whether the laboratory has research capabilities. One of the hot buttons in food safety today is validation studies. Are your products safe? Will they support the growth of pathogens or organisms causing economic spoilage? Is your product lethal to pathogens? Is your product acidic naturally and should the pH of the product be adjusted to neutral before testing? Is the product high in sugar and should the analysis include the use of osmophilic media? Again, your products define potential needs.
Fast and Responsive: Most customers want results quickly. It is an age of instant gratification, so many seem to think that microbiological test results will be done yesterday. Time frames for completing work must be addressed upfront, especially when samples are submitted or collected at the end of a week. The contract laboratory should provide its customers with a list of methods and how long it will take from receipt of samples to the submission of a report. Customers should be asking how accurate the rapid methods that the laboratory is using are and have those rapid methods been validated for use with the customer’s matrix by either the laboratory or the test kit manufacturer.
References: Always ask for client references when looking for a contract laboratory. And ask whether the operation can provide references that produce similar products or are of a similar size to your operation. There are times when the “little guy” may be ignored if the big customer has needs. Try to determine from the references whether they have been served well, which goes beyond simply providing results.
Pickup Program: One of the services offered by many contract microbiology laboratories is a pickup service. The laboratory works with their customers and arranges schedules for regular pickups of samples. As part of this service, the laboratory will provide information on how to collect, label and package samples. Of course, sample collection, labeling and packaging should be included among the documented quality procedures for each and every processor. This is a service, however, not a requirement.
Pickup services are something that processors should examine closely. If samples are not picked up, it is up to the processor to pack and ship the samples. Shipping entails ensuring that the sample remains in good condition (using blue ice and insulated shipping containers). Shipping adds costs and takes work to do properly. Weigh the pros and cons as part of the selection process.
Audits: The laboratory that is being considered should welcome a visit or audit by a potential customer. If they do not, consider dropping them from the list. It is just like auditing an ingredient or raw material supplier. If they don’t want you to visit, you don’t want to do business with them. A visit allows the processor to see the facilities, meet the people and get to know with whom they will be working.
When a company visits the laboratory, one of the things it should do is examine what the laboratory’s reports look like. This should include laboratory reports, COAs that they generate, technical reports and any other information that you may wish them to prepare for you. They should be able to do this, as it is not hard to sanitize a report.
Check-Sample Program: One of the basic elements for ensuring competence for most laboratories is a check-sample program. As part of the evaluation of the facility, ask whether they participate in such a program. These are designed to evaluate the technicians doing the work using samples prepared by a third party. Participation in a third-party, check-sample program is also a requirement for being ISO certified. Many of the global food processors actually run their own check-sample programs with the laboratories with which they work.
Data Interpretation: When looking for a microbiological laboratory, find out whether they will tell you what the data mean. Will they interpret them for you? This is often essential for the small-to-medium-size companies that don’t have the technical expertise on staff. They need to know more than the numbers; they need to know what those numbers mean and how they should react.
Data interpretation has been a bone of contention in recent years. When I entered the food industry in 1977, most contract microbiology laboratories would provide not only results but also an interpretation of those results. That has changed today as interpretation seems to be deemed consulting. In addition, providing an interpretation of results is being treated as a potential liability by the contract laboratories. Again, for small processors, this is often an absolute necessity. One would hope that the contract laboratory industry might consider rethinking their position.
Sense of Urgency: The laboratory should treat all samples equally, that is, with a sense of urgency. If you feel that the contract laboratory is not providing you with the service expected, let the laboratory know. Ask whether the laboratory will work on Fridays and weekends. And if they will, ask whether you will be invoiced for the extra time.
Experience with Your Products: The contract laboratory should have experience with your product types and understand not only how they are manufactured but also what kind of issues would be associated with these products. During my work with my clients, I have had to recommend that they should repeat work for which they have contracted. The processors spent a great deal of money on challenge studies, but the work had not been done properly. The microorganisms used had not been properly conditioned, nor had the proper inoculation protocols been followed. The study would not have withstood the scrutiny of a validation review.
Ability to Suggest More Appropriate or Other Tests: A good laboratory will not only do the actual testing or research, but they also should be able to help the client determine what tests should be done. This kind of support is especially valuable to small companies or those without in-house technical expertise. One hot topic today, thanks to the Food Safety Modernization Act, is environmental monitoring. Many laboratories will assist with the development of the program, which would include determining sampling sites, collection and analysis of the samples. The program for monitoring should focus on what is needed to meet the letter and spirit of the regulation.
Cost: Cost should really be the last thing a company should consider when selecting a laboratory. The old adage “you get what you pay for” tends to ring true in this business as it does in most others. It is always a good idea to shop around so one knows what the going price for certain tests actually is.
When selecting an ingredient, raw material or packaging supplier, many companies utilize a vendor questionnaire or checklist. A similar approach may be used when evaluating laboratories. The information noted above plus other questions and contact information may be summarized in a questionnaire and submitted to the laboratory or laboratories in question. This is, as noted, a preliminary step for vendor approval and may be used as a preliminary step when selecting a laboratory. Those operations that do not respond to the questionnaire or fail to fill it out properly may be eliminated from the search.
Things to Watch Out For
There are several issues that companies may want to consider when evaluating contract laboratories. These issues mostly pertain to interactions between a laboratory and processor but may affect actual performance.
Factory Mentality: As companies offering contract laboratory services have grown, they have tried to become more efficient and have adopted what might be called an assembly-line approach or factory mentality. Samples go into the queue, get processed by one of the technicians and signed off by a manager. This is efficient but does not create any ownership of the project. Everything is a number, not your sample. Smaller laboratories often offer more personal service, but their costs may be higher.
Another issue with the factory approach is that sometimes the “rapid technique” may not be applicable to a specific product. A client with whom I once worked had never had a product go out of specification until they switched laboratories. As soon as they switched, they began getting reports of high counts. The only change to operations was the switch to the new laboratory. It turned out that the laboratory was using a rapid method that simply did not work for that particular product. They had failed to validate the efficacy of the new testing protocol against the old.
Too Diverse: Another issue is that many laboratories want to be all things to all people. They want to do all types of testing, offer consulting services, do training and perform other services. Sometimes these operations bite off more than they can chew. They simply don’t do everything well. One question that should be asked of a potential contractor is whether they do all the work themselves. Many operations say they can do certain tests, but what they are doing is subcontracting them out to another laboratory. This increases costs, lengthens turnaround times, and, as a customer, one never knows how the product was actually handled and tested. If specific tests are needed, find a laboratory that does that work; don’t have work subcontracted.
Customer Service: The biggest issue is customer service. Will the laboratory meet your needs and are you both comfortable with them and confident in their expertise?
I have worked with a laboratory in California for many years. The owner is very knowledgeable and has worked with many start-ups over the years. As these companies grew, some were informed by their new customers that they had to change laboratories to one from the customer-approved list. So what happened next? They bid the company that helped them build their business adieu and went to the “approved laboratory.” Within weeks, they were on the phone to the old laboratory asking for help with the information provided by the new and approved laboratory that supplied neither advice nor interpretation.
Summary
Selecting a contract laboratory for your needs should be as rigorous as the programs to select your suppiers. Look at what the U.S. Food and Drug Administration asks in 21 C.F.R. Part 117 Subpart G for suppliers.[1] Selection criteria for laboratories should be stringent, especially with microbiology laboratories, as they are an integral part of your food safety program. Figure 1 shows how a procedure for accomplishing this should be done. Our example focuses on selecting a microbiology laboratory, but you could use the same basic protocol for selecting a chemistry or a research and development laboratory.
Finally, almost all processors are subjected to some form of third-party audit. The audits and auditors would not be doing their jobs if they did not include contract laboratories and how they are selected and managed in the audit. These operations should be your partners in quality and safety, so look for the best—a process that begins with tough selection criteria.
Richard F. Stier is a consulting food scientist and a member of the Editorial Advisory Board of Food Safety Magazine. He can be reached at rickstier4@aol.com.
References
1. www.federalregister.gov/articles/2015/09/17/2015-21920/current-good-manufacturing-practice-hazard-analysis-and-risk-based-preventive-controls-for-human.
2. International Organization for Standardization. 1999. “General Requirements for the Competence of Testing and Calibration Laboratories: ISO 17025.” Geneva, Switzerland.
Looking for quick answers on food safety topics?
Try Ask FSM, our new smart AI search tool.
Ask FSM →








